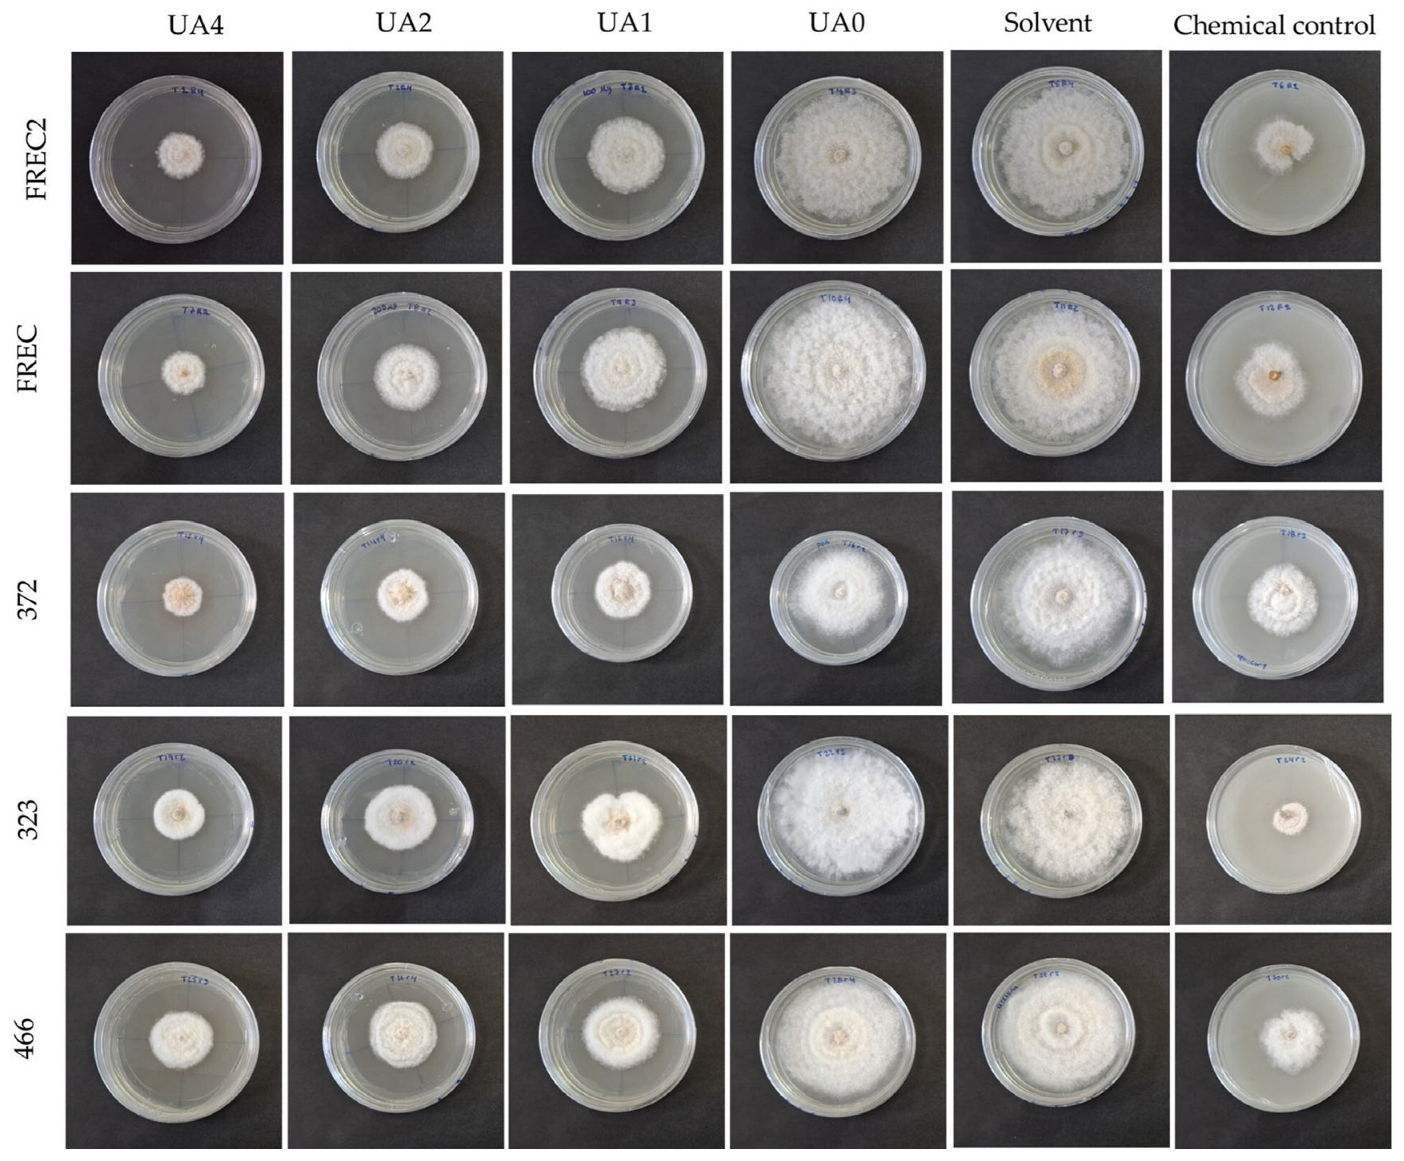
Horticulturae 11 00812 g003

In Vitro Sensitivity of Isolates of Neopestalotiopsis rosae, Causal Agent of Strawberry Crown Rot, to Usnic Acid
Abstract
1. Introduction
2. Materials and Methods
2.1. Fungal Isolates
2.2. In Vitro Sensitivity Assay of N. rosae Isolates to Usnic Acid
2.3. Mycelial Growth and Percentage of Inhibition (%)
2.4. Final Sporulation
2.5. In Vivo Assay of Usnic Acid in Strawberry Seedlings Inoculated with N. rosae Isolates
2.6. H2O2 Determination
2.7. MDA Determination
2.8. Phenylalanine Ammonia Lyase Activity (EC. 4.3.1.5)
2.9. Statistical Analysis
3. Results
3.1. Mycelial Growth and Percentage of Inhibition (%)
3.2. Mean Inhibitory Concentration
3.3. Mycelial Growth of N. rosae Exposed to Different Concentrations of Usnic Acid
3.4. Sporulation
3.5. H2O2 Content in Strawberry Plants cv. Albion Inoculated with N. rosae and Exposed to Different Concentrations of Usnic Acid
3.6. MDA Content in Strawberry Plants cv. Albion Inoculated with N. rosae and Exposed to Different Concentrations of Usnic Acid
3.7. Phenylalanine Ammonia-Lyase Activity (PAL) in Strawberry cv. Albion Inoculated with N. rosae and Exposed to Different Concentrations of Usnic Acid
3.8. Severity Percentage in Strawberry Plants cv. Albion Inoculated with N. rosae and Exposed to Different Concentrations of Usnic Acid
4. Discussion
4.1. Mycelial Growth and Percentage of Inhibition (%)
4.2. Effect of Usnic Acid on Structures of N. rosae
4.3. Mean Inhibitory Concentration (IC50)
4.4. Final Sporulation
4.5. H2O2 Content in Strawberry Plants Inoculated with N. rosae Strains Exposed to Different Concentrations of Usnic Acid
4.6. MDA Content in Strawberry Plants Inoculated with N. rosae Strains and Exposed to Different Concentrations of Usnic Acid
4.7. Phenylalanine Ammonia Lyase Activity in Strawberry Plants Inoculated with N. rosae Strains and Exposed to Different Concentrations of Usnic Acid
4.8. Severity Percentage in Strawberry Plants Inoculated with N. rosae Strains and Exposed to Different Concentrations of Usnic Acid
5. Conclusions
Supplementary Materials
Author Contributions
Funding
Data Availability Statement
Acknowledgments
Conflicts of Interest
References
- Yang, R.; Liu, P.; Ye, W.; Chen, Y.; Wei, D.; Qiao, C.; Zhou, B.; Xiao, J. Biological Control of Root Rot of Strawberry by Bacillus amyloliquefaciens Strains CMS5 and CMR12. J. Fungi 2024, 10, 410. [Google Scholar] [CrossRef]
- Dirección General Del Servicio de Información Agroalimentaria y Pesquera|Gobierno|Gob. Mx. Available online: https://www.gob.mx/agricultura/dgsiap (accessed on 21 May 2025).
- Hong, S.; Kim, T.Y.; Won, S.J.; Moon, J.H.; Ajuna, H.B.; Kim, K.Y.; Ahn, Y.S. Control of Fungal Diseases and Fruit Yield Improvement of Strawberry Using Bacillus velezensis CE 100. Microorganisms 2022, 10, 365. [Google Scholar] [CrossRef]
- Schierling, T.E.; Voegele, R.T.; El-Hasan, A. First Report on the Emergence of Neopestalotiopsis rosae as a Severe Economic Threat to Strawberry Production in Germany. Microorganisms 2025, 13, 6. [Google Scholar] [CrossRef]
- Morales-Mora, L.A.; Andrade-Hoyos, P.; Valencia-de Ita, M.A.; Romero-Arenas, O.; Silva-Rojas, H.V.; Contreras-Paredes, C.A. Characterization of Strawberry Associated Fungi and in Vitro Antagonistic Effect of Trichoderma harzianum. Rev. Mex. Fitopatol. 2020, 38, 434–449. [Google Scholar] [CrossRef]
- Rebollar-Alviter, A.; Silva-Rojas, H.V.; Fuentes-Aragón, D.; Acosta-González, U.; Martínez-Ruiz, M.; Parra-Robles, B.E. An Emerging Strawberry Fungal Disease Associated with Root Rot, Crown Rot and Leaf Spot Caused by Neopestalotiopsis rosae in Mexico. Plant Dis. 2020, 104, 2054–2059. [Google Scholar] [CrossRef]
- Garay-Serrano, E.; Cruz-Esteban, S.; Pavia, S.P.F.; Alvarado, G.R.; Gómez-Dorantes, N. Pathogenic Microorganisms Infecting Berries in Mexico. Int. J. Agric. Biol. 2021, 25, 1007–1015. [Google Scholar] [CrossRef]
- Dholi, P.K.; Khatiwada, P.; Basnet, B.; Bhandari, S. An Extensive Review of Strawberry (Fragaria × ananassa) Diseases and Integrated Management Approaches: Current Understanding and Future Directions. Fundam. Appl. Agric. 2023, 8, 655–667. [Google Scholar] [CrossRef]
- Acosta-González, U.; Leyva-Mir, S.G.; Silva-Rojas, H.V.; Rebollar-Alviter, A. Preventive and Curative Effects of Treatments to Manage Strawberry Root and Crown Rot Caused by Neopestalotiopsis rosae. Plant Dis. 2024, 108, 1278–1288. [Google Scholar] [CrossRef] [PubMed]
- Essa, T.A.; Kamel, S.M.; Ismail, A.M.; El-Ganainy, S. Characterization and Chemical Control of Neopestalotiopsis rosae the Causal Agent of Strawberry Root and Crown Rot in Egypt. Egypt. J. Phytopathol. 2018, 46, 1–19. [Google Scholar] [CrossRef]
- Sun, Q.; Harishchandra, D.; Jia, J.; Zuo, Q.; Zhang, G.; Wang, Q.; Yan, J.; Zhang, W.; Li, X. Role of Neopestalotiopsis rosae in Causing Root Rot of Strawberry in Beijing, China. Crop Prot. 2021, 147, 105710. [Google Scholar] [CrossRef]
- Wu, H.Y.; Tsai, C.Y.; Wu, Y.M.; Ariyawansa, H.A.; Chung, C.L.; Chung, P.C. First Report of Neopestalotiopsis rosae Causing Leaf Blight and Crown Rot on Strawberry in Taiwan. Plant Dis. 2021, 105, 487. [Google Scholar] [CrossRef]
- Lawrence, D.P.; Brittain, G.D.; Aglave, B.; Sances, F.V. First Report of Neopestalotiopsis rosae Causing Crown and Root Rot of Strawberry in California. Plant Dis. 2023, 107, 566. [Google Scholar] [CrossRef]
- Dardani, G.; Martino, I.; Aloi, F.; Carli, C.; Giordano, R.; Spadaro, D.; Guarnaccia, V. Characterization of Neopestalotiopsis Species Associated with Strawberry Crown Rot in Italy. Agronomy 2025, 15, 422. [Google Scholar] [CrossRef]
- Fungicide Resistance Action Committee FRAC Fungicide Resistance Action Committee FRAC. Available online: https://www.frac.info/ (accessed on 21 May 2025).
- Liu, P.; Yang, R.; Wang, Z.; Ma, Y.; Ren, W.; Wei, D.; Ye, W. Biocontrol Potential of Trichoderma asperellum CMT10 against Strawberry Root Rot Disease. Horticulturae 2024, 10, 246. [Google Scholar] [CrossRef]
- Madariaga-Mazón, A.; Hernández-Alvarado, R.B.; Noriega-Colima, K.O.; Osnaya-Hernández, A.; Martinez-Mayorga, K. Toxicity of Secondary Metabolites. Phys. Sci. Rev. 2019, 4. [Google Scholar] [CrossRef]
- Petrović, E.; Vrandečić, K.; Ćosić, J.; Siber, T.; Godena, S. Antifungal Efficacy of Essential Oils and Their Predominant Components Against Olive Fungal Pathogens. Agriculture 2025, 15, 340. [Google Scholar] [CrossRef]
- Pham, D.Q.; Pham, H.T.; Han, J.W.; Nguyen, T.H.; Nguyen, H.T.; Nguyen, T.D.; Nguyen, T.T.T.; Ho, C.T.; Pham, H.M.; Vu, H.D.; et al. Extracts and Metabolites Derived from the Leaves of Cassia alata L. Exhibit in Vitro and in Vivo Antimicrobial Activities against Fungal and Bacterial Plant Pathogens. Ind. Crops Prod. 2021, 166, 113465. [Google Scholar] [CrossRef]
- Hussain, A.Y.; Hussein, H.J.; Al-Rubaye, F.A. Antifungal Activity of the Secondary Metabolites Extracted from Carthamus tinctorius L. against Aspergillus Species Isolated from Stored Medicinal Plants Seeds in the Iraqi Markets. Clin. Schizophr. Relat. Psychoses 2021, 15, 1–6. [Google Scholar] [CrossRef]
- Croce, N.; Pitaro, M.; Gallo, V.; Antonini, G. Toxicity of Usnic Acid: A Narrative Review. J. Toxicol. 2022, 2022, 8244340. [Google Scholar] [CrossRef]
- Ingólfsdóttr, K. Usnic Acid. Phytochemistry 2002, 61, 729–736. [Google Scholar] [CrossRef]
- Paguirigan, J.A.; Liu, R.; Im, S.M.; Hur, J.S.; Kim, W. Evaluation of Antimicrobial Properties of Lichen Substances against Plant Pathogens. Plant. Pathol. J. 2022, 38, 25. [Google Scholar] [CrossRef] [PubMed]
- Freitas, L.D.S.; Caprara, C.D.S.C.; Volcão, L.M.; Brum, R.D.L.; Barbosa, I.; Da Silva, F.M.R.; Ramos, D.F. Usnic Acid (+) Enantiomer in Alternative In Vitro Control of Burkholderia cepacia and Allelopathic Effect. Appl. Vitr. Toxicol. 2022, 8, 58–63. [Google Scholar] [CrossRef]
- Cintra, L.S.; Britto, A.C.C.; Tozatti, M.G.; Vasconcelos, M.A.L.; Martins, C.H.G.; Silva, M.L.A.; Januário, A.H.; Pauletti, P.M.; Tavares, D.C.; Cunha, W.R. Antimicrobial Activity of the Natural Compounds Rosmarinic Acid, Usnic Acid and Difrataic Acid against Phytopathogens. In Development and its Applications in Scientific Knowledge; Seven Editora: São José dos Pinhais, Brazil, 2023. [Google Scholar] [CrossRef]
- Abbott, W.S. A Method of Computing the Effectiveness of an Insecticide. J. Econ. Entomol. 1925, 18, 265–267. [Google Scholar] [CrossRef]
- Xoca-Orozco, L.Á.; Cortez-Fonseca, K.; Luna López, C.; Hernández-Mendoza, G.; de Flores-Sierra, J.J.; Chacón-López, M.A.; Aguilera-Aguirre, S. Inhibición in Vitro de Hongos Fitopatógenos Utilizando Extractos de Muérdago Mexicano (Psittacanthus calyculatus). Ecosist. Recur. Agropec. 2022, 9, e3431. [Google Scholar] [CrossRef]
- Steiner, A.A. A Universal Method for Preparing Nutrient Solutions of a Certain Desired Composition. Plant Soil. 1961, 15, 134–154. [Google Scholar] [CrossRef]
- Lechowski, Z.; Mej, E.; Bialczyk, J. Accumulation of Biomass and Some Macroelements in Tomato Plants Grown in Media with (+)-Usnic Acid. Environ. Exp. Bot. 2006, 56, 239–244. [Google Scholar] [CrossRef]
- Meier, U. Etapas de Desarrollo de Las Plantas Monocotiledóneas y Dicotiledóneas: BBCH Monografia. BBCH Monogr. 2018, 1, 82–85. [Google Scholar] [CrossRef]
- Velikova, V.; Yordanov, I.; Edreva, A. Oxidative Stress and Some Antioxidant Systems in Acid Rain-Treated Bean Plants: Protective Role of Exogenous Polyamines. Plant Sci. 2000, 151, 59–66. [Google Scholar] [CrossRef]
- Sykłowska-Baranek, K.; Pietrosiuk, A.; Naliwajski, M.R.; Kawiak, A.; Jeziorek, M.; Wyderska, S.; Łojkowska, E.; Chinou, I. Effect of L-Phenylalanine on PAL Activity and Production of Naphthoquinone Pigments in Suspension Cultures of Arnebia euchroma (Royle) Johnst. Vitr. Cell. Dev. Biol.–Plant 2012, 48, 555–564. [Google Scholar] [CrossRef]
- Mier, T.; Rivera-Becerril, F.; Ayala-Zermeño, M.; Toriello, C.; Ogarrio, S.; Ulloa, M. Métodos Experimentales Para El Estudio de Hongos Microscópicos; Biology Institute-UAM: Mexico City, Mexico, 2013; ISBN 9786070248276. [Google Scholar]
- Maciag-Dorszyńska, M.; Wegrzyn, G.; Guzow-Krzemińska, B. Antibacterial Activity of Lichen Secondary Metabolite Usnic Acid Is Primarily Caused by Inhibition of RNA and DNA Synthesis. FEMS Microbiol. Lett. 2014, 353, 57–62. [Google Scholar] [CrossRef]
- Romagni, J.G.; Meazza, G.; Nanayakkara, N.P.D.; Dayan, F.E. The Phytotoxic Lichen Metabolite, Usnic Acid, Is a Potent Inhibitor of Plant p-Hydroxyphenylpyruvate Dioxygenase. FEBS Lett. 2000, 480, 301–305. [Google Scholar] [CrossRef] [PubMed]
- Yu, X.H.; Dong, J.; Fan, C.P.; Chen, M.X.; Li, M.; Zheng, B.F.; Hu, Y.F.; Lin, H.Y.; Yang, G.F. Discovery and Development of 4-Hydroxyphenylpyruvate Dioxygenase as a Novel Crop Fungicide Target. J. Agric. Food Chem. 2023, 71, 19396–19407. [Google Scholar] [CrossRef] [PubMed]
- Zhang, C.W.; Zhong, X.J.; Zhao, Y.S.; Rajoka, M.S.R.; Hashmi, M.H.; Zhai, P.; Song, X. Antifungal Natural Products and Their Derivatives: A Review of Their Activity and Mechanism of Actions. Pharmacol. Res.–Mod. Chin. Med. 2023, 7, 100262. [Google Scholar] [CrossRef]
- Ndikuryayo, F.; Moosavi, B.; Yang, W.C.; Yang, G.F. 4-Hydroxyphenylpyruvate Dioxygenase Inhibitors: From Chemical Biology to Agrochemicals. J. Agric. Food. Chem. 2017, 65, 8523–8537. [Google Scholar] [CrossRef]
- Duke, S.O.; Pan, Z.; Bajsa-Hirschel, J.; Tamang, P.; Hammerschmidt, R.; Lorsbach, B.A.; Sparks, T.C. Molecular Targets of Herbicides and Fungicides—Are There Useful Overlaps for Fungicide Discovery? J Agric. Food Chem. 2023, 71, 20532–20548. [Google Scholar] [CrossRef]
- Qin, Y.; Xia, Y. Melanin in Fungi: Advances in Structure, Biosynthesis, Regulation, and Metabolic Engineering. Microb Cell Fact. 2024, 23, 334. [Google Scholar] [CrossRef]
- Ramachandra, S.K. The Role of Melanin in Plant Pathogenic Fungi: Insights into Structure, Biosynthesis, and Function. Plant Biol. Crop Res. 2023, 6, 1090. [Google Scholar]
- Eisenman, H.C.; Greer, E.M.; McGrail, C.W. The Role of Melanins in Melanotic Fungi for Pathogenesis and Environmental Survival. Appl. Microbiol. Biotechnol. 2020, 104, 4247–4257. [Google Scholar] [CrossRef]
- Wang, Y.; Wang, Z.; Jibril, S.M.; Wei, M.; Pu, X.; Yang, C.; Ma, C.; Wu, Q.; Liu, L.; Quan, Y.; et al. Transcriptome and Quasi-Targeted Metabolome Analyze Overexpression of 4-Hydroxyphenylpyruvate Dioxygenase Alleviates Fungal Toxicity of 9-Phenanthrol in Magnaporthe oryzae. Int. J. Mol. Sci. 2022, 23, 7116. [Google Scholar] [CrossRef]
- Nunes, L.R.; De Oliveira, R.C.; Leite, D.B.; Da Silva, V.S.; Dos Reis Marques, E.; Da Silva Ferreira, M.E.; Duarte Ribeiro, D.C.; De Souza Bernardes, L.Â.; Goldman, M.H.S.; Puccia, R.; et al. Transcriptome Analysis of Paracoccidioides brasiliensis Cells Undergoing Mycelium-to-Yeast Transition. Eukaryot. Cell 2005, 4, 2115–2128. [Google Scholar] [CrossRef]
- Viriyakosol, S.; Singhania, A.; Fierer, J.; Goldberg, J.; Kirkland, T.N.; Woelk, C.H. Gene Expression in Human Fungal Pathogen Coccidioides immitis Changes as Arthroconidia Differentiate into Spherules and Mature. BMC Microbiol. 2013, 13, 121. [Google Scholar] [CrossRef]
- Holetz, F.B.; Pessini, G.L.; Sanches, N.R.; Cortez, D.A.G.; Nakamura, C.V.; Dias Filho, B.P. Screening of Some Plants Used in the Brazilian Folk Medicine for the Treatment of Infectious Diseases. Mem. Inst. Oswaldo Cruz. 2002, 97, 1027–1031. [Google Scholar] [CrossRef]
- Su, Y.Y.; Qi, Y.L.; Cai, L. Induction of Sporulation in Plant Pathogenic Fungi. Mycology 2012, 3, 195–200. [Google Scholar] [CrossRef]
- Ávila-Hernández, J.G.; León-Ramírez, C.G.; del Abraham-Juárez, M.R.; Tlapal-Bolaños, B.; Olalde-Portugal, V.; Délano-Frier, J.P.; Martínez-Antonio, A.; Aguilar-Zárate, P. Neopestalotiopsis spp.: A Threat to Strawberry Production and Management. Horticulturae 2025, 11, 288. [Google Scholar] [CrossRef]
- Alonzo, G.; Baggio, J.S.; Peres, N.A. Effect of Fumigants on Inoculum of Neopestalotiopsis spp. in Strawberry Crowns and Soil. Plant Dis. 2025, 109, 902–908. [Google Scholar] [CrossRef] [PubMed]
- Mellersh, D.G.; Foulds, I.V.; Higgins, V.J.; Heath, M.C. H2O2 Plays Different Roles in Determining Penetration Failure in Three Diverse Plant–Fungal Interactions. Plant J. 2002, 29, 257–268. [Google Scholar] [CrossRef]
- Prokopiev, I.A.; Filippova, G.V. Effect of (+) and (–) Usnic Acid on Physiological, Biochemical, and Cytological Characteristics of Allium fistulosum Seeds. Russ. J. Plant Physiol. 2020, 67, 1046–1053. [Google Scholar] [CrossRef]
- Huang, Y.; Li, J.; Nong, C.; Lin, T.; Fang, L.; Feng, X.; Chen, Y.; Lin, Y.; Lai, Z.; Miao, L. Piriformospora indica Enhances Resistance to Fusarium Wilt in Strawberry by Increasing the Activity of Superoxide Dismutase, Peroxidase, and Catalase, While Reducing the Content of Malondialdehyde in the Roots. Horticulturae 2024, 10, 240. [Google Scholar] [CrossRef]
- Kikowska, M.; Thiem, B.; Jafernik, K.; Klimek-Szczykutowicz, M.; Studzińska-Sroka, E.; Ekiert, H.; Szopa, A. Effect of Elicitation with (+)-Usnic Acid on Accumulation of Phenolic Acids and Flavonoids in Agitated Microshoots of Eryngium alpinum L. Molecules 2021, 26, 5532. Molecules 2021, 26, 5532. [Google Scholar] [CrossRef]
- Agati, G.; Azzarello, E.; Pollastri, S.; Tattini, M. Flavonoids as Antioxidants in Plants: Location and Functional Significance. Plant Sci. 2012, 196, 67–76. [Google Scholar] [CrossRef]
- Mierziak, J.; Kostyn, K.; Kulma, A. Flavonoids as Important Molecules of Plant Interactions with the Environment. Molecules 2014, 19, 16240–16265. [Google Scholar] [CrossRef] [PubMed]
- Wei, W.; Orfei, B.; Scian, A.; Del Buono, D.; Paglialunga, M.; Tolisano, C.; Priolo, D.; Moretti, C.; Buonaurio, R. Biogenic Zinc Oxide Nanoparticles Protect Tomato Plants Against Pseudomonas syringae Pv. Tomato. Horticulturae 2025, 11, 431. [Google Scholar] [CrossRef]
- Mandal, S.; Kar, I.; Mukherjee, A.K.; Acharya, P.; Bekatorou, A.; Guevara-Garcia, A.A.; Thilmony, R. Elicitor-Induced Defense Responses in Solanum lycopersicum against Ralstonia solanacearum. Sci. World J. 2013, 2013, 561056. [Google Scholar] [CrossRef]
- You, X.; Fang, H.; Wang, R.; Wang, G.L.; Ning, Y. Phenylalanine Ammonia Lyases Mediate Broad-Spectrum Resistance to Pathogens and Insect Pests in Plants. Sci. Bull. 2020, 65, 1425–1427. [Google Scholar] [CrossRef]

| Code | Treatment | Code | Treatment |
|---|---|---|---|
| T1 | FREC2 + UA 400 µg/mL | T11 | 323 + NaOH (solvent UA) |
| T2 | FREC2 + Chemical control | T12 | 323 + distilled water |
| T3 | FREC2 + NaOH (solvent UA) | T13 | 372 + UA 400 µg/mL |
| T4 | FREC2 + distilled water | T14 | 372 + Chemical control |
| T5 | FREC + UA 400 µg/mL | T15 | 372 + NaOH (solvent UA) |
| T6 | FREC + Chemical control | T16 | 372 + distilled water |
| T7 | FREC + NaOH (solvent UA) | T17 | 466 + UA 400 µg/mL |
| T8 | FREC + distilled water | T18 | 466 + Chemical control |
| T9 | 323 + UA 400 µg/mL | T19 | 466 + NaOH (solvent UA) |
| T10 | 323 + Chemical control | T20 | 466 + distilled water |
| Isolate | * IC50 (μg/mL) | Fiducial Limits (Lower-Upper) | Probit Equation | p-Value |
|---|---|---|---|---|
| FREC2 | 247.112 | 217.842–277.984 | Y= −0.350276 + 0.0014175 X | 0.000 |
| FREC | 354.327 | 300.423–449.182 | Y= −0.305939 + 0.0008634 X | 0.000 |
| 372 | 255.439 | 231.684–280.885 | Y= −0.444146 + 0.0017388 X | 0.000 |
| 323 | 254.278 | 227.583–282.972 | Y= −0.393141 + 0.0015461 X | 0.000 |
| 466 | 385.798 | 350.936–433.877 | Y= −0.623589 + 0.0016164 X | 0.000 |
| Isolated | FREC2 | FREC | 372 | 323 | 466 |
|---|---|---|---|---|---|
| Treatment (μg/mL) | No. Spores mL−1 | ||||
| 400 | 2.4 × 104 a | 3.0 × 103 a | 1.2 × 105 a | 1.1 × 103 a | 1.3 × 105 a |
| 200 | 1.0 × 104 a | 6.2 × 103 a | 2.5 × 105 a | 9.6 × 104 a | 6.7 × 104 a |
| 100 | 5.7 × 104 a | 5.0 × 104 a | 6.5 × 104 a | 7.5 × 102 a | 2.7 × 104 a |
| 0 | 1.6 × 104 a | 2.3 × 105 a | 7.3 × 104 a | 7.4 × 104 a | 8.5 × 104 a |
| Solvent | 5.4 × 104 a | 1.5 × 105 a | 6.4 × 104 a | 9.6 × 104 a | 3.2 × 105 a |
| Chemical control | 1.3 × 104 a | 4.5 × 104 a | 5.5 × 104 a | 4.6 × 105 a | 2.6 × 103 a |
Disclaimer/Publisher’s Note: The statements, opinions and data contained in all publications are solely those of the individual author(s) and contributor(s) and not of MDPI and/or the editor(s). MDPI and/or the editor(s) disclaim responsibility for any injury to people or property resulting from any ideas, methods, instructions or products referred to in the content. |
© 2025 by the authors. Licensee MDPI, Basel, Switzerland. This article is an open access article distributed under the terms and conditions of the Creative Commons Attribution (CC BY) license (https://creativecommons.org/licenses/by/4.0/).
Share and Cite
Castro-Rosalez, L.; Juárez-Maldonado, A.; Benavides-Mendoza, A.; González-Morales, S.; García-León, E.; Rebollar-Alviter, A.; Pérez-Labrada, F. In Vitro Sensitivity of Isolates of Neopestalotiopsis rosae, Causal Agent of Strawberry Crown Rot, to Usnic Acid. Horticulturae 2025, 11, 812. https://doi.org/10.3390/horticulturae11070812
Castro-Rosalez L, Juárez-Maldonado A, Benavides-Mendoza A, González-Morales S, García-León E, Rebollar-Alviter A, Pérez-Labrada F. In Vitro Sensitivity of Isolates of Neopestalotiopsis rosae, Causal Agent of Strawberry Crown Rot, to Usnic Acid. Horticulturae. 2025; 11(7):812. https://doi.org/10.3390/horticulturae11070812
Chicago/Turabian StyleCastro-Rosalez, Laura, Antonio Juárez-Maldonado, Adalberto Benavides-Mendoza, Susana González-Morales, Elizabeth García-León, Angel Rebollar-Alviter, and Fabián Pérez-Labrada. 2025. "In Vitro Sensitivity of Isolates of Neopestalotiopsis rosae, Causal Agent of Strawberry Crown Rot, to Usnic Acid" Horticulturae 11, no. 7: 812. https://doi.org/10.3390/horticulturae11070812
APA StyleCastro-Rosalez, L., Juárez-Maldonado, A., Benavides-Mendoza, A., González-Morales, S., García-León, E., Rebollar-Alviter, A., & Pérez-Labrada, F. (2025). In Vitro Sensitivity of Isolates of Neopestalotiopsis rosae, Causal Agent of Strawberry Crown Rot, to Usnic Acid. Horticulturae, 11(7), 812. https://doi.org/10.3390/horticulturae11070812

